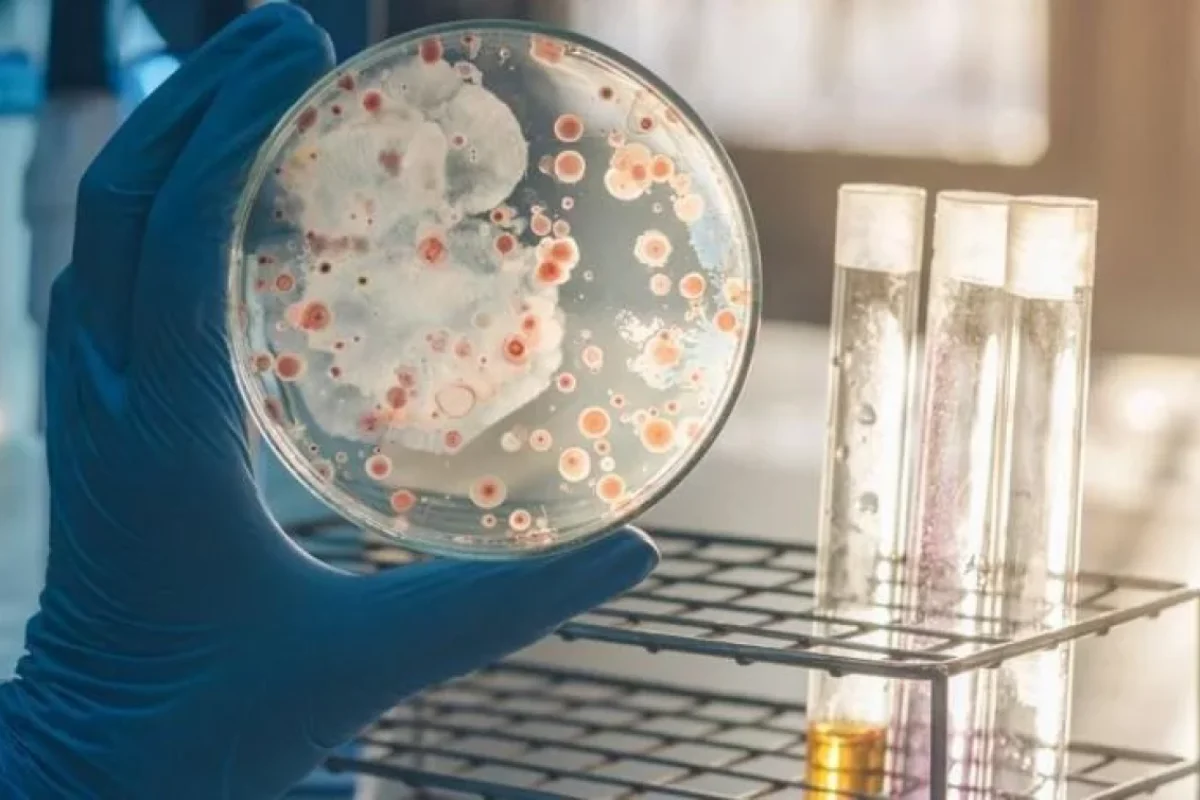
Bu məlhəmlə yaralarınız sağalacaq

Bu məlhəmlə yaralarınız sağalacaq
Sağlamlıq
Sağlamlıq
Bəzən bilinən, bəzən isə bilinməyən səbəbdən bədəndə yaralar əmələ gəlir. Və ya yıxılırıq, əlimizi bıçaq kəsir. Bəzi hallarda isə yaralar gec sağalır, xoşagəlməz görüntü yaradır.
News24.Az xəbər verir ki, mütəxəssislər yaranı sağaltmaq üçün kefirdən istifadəni məsləhət görür. Bu zaman həm yara tez sağalacaq, həm də izi qalmayacaq.
Bəs, onu necə istifadə etmək olar?
1 xörək qaşığı qovun tumuna 0,5 stəkan su töküb, 5 dəqiqə qaynadın. Soyuduqdan sonra sudan ½ stəkan götürüb, 1 stəkan kefirlə qarışdırın. Məlhəmə 1 çay qaşığı portağal və ya limon şirəsi əlavə etmək olar. Yaraları bu suya batırılmış pambıqla silin. Eyni zamanda ayaqları tez-tez şişənlər bu məlhəmdən gündə üç dəfə içsin.
Bədənin zədələnmiş yerinə kefirlə kompres qoymaq yaranı tez sağaldır. O, ləkə əmələ gəlməsinin qarşısını alıb, qan yığılmasına imkan verməyəcək. /Axşam.az




